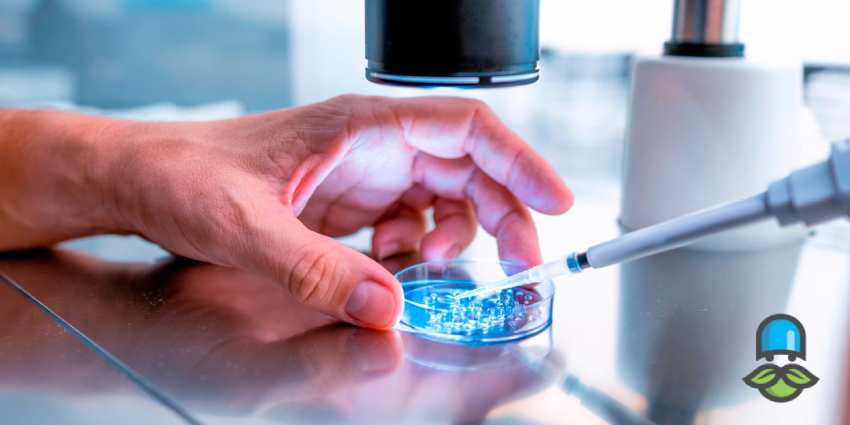
پانکچر چگونه انجام میشود؟

عمل پانکچر
میدانید عمل پانکچر چیست؟ بسیاری از زوجهایی که وارد درمان ناباروری میشوند، نام عمل پانکچر را بارها از پزشک خود میشنوند، اما این عمل چیست و چرا تا این اندازه در IVF مهم است؟ عمل پانکچر همان مرحلهای است که در آن پزشک تخمکها را از فولیکولهای بالغ خارج مینماید؛ مرحلهای کوتاه اما تعیینکننده که کیفیت آن میتواند سرنوشت کل چرخه را تحتتاثیر خود قرار دهد.
آیا درد دارد؟ چقدر طول میکشد؟ آیا نیاز به بیهوشی دارد؟ این نگرانیها برای بیماران طبیعی است و دانستن جزئیات میتواند اضطراب را به اطمینان تبدیل نماید. در این مقاله آقای دارو، همه نکاتی که لازم است درباره عمل پانکچر بدانید را خواهیم گفت.
عمل پانکچر چیست؟
عمل پانکچر یک روش پزشکی در درمانهای کمکباروری محسوب میشود که طی آن پزشک با کمک سونوگرافی واژینال و یک سوزن باریک، تخمکهای رسیده را از داخل فولیکولهای تخمدان خارج میکند. این مرحله بخشی حیاتی در فرآیند IVF محسوب میشود و به طور معمول تحت بیهوشی کوتاه انجام میگیرد.
پانکچر چگونه انجام میشود؟
در درمان ناباروری که با روشهای نوین میشود، نقطه مشترک اغلب پروتکلها رسیدن به لحظهای است که باید تخمکها با دقت از تخمدان برداشت شوند. این مرحله همان پانکچر است که با کمک OPU یا تخمکگیری هدایت میشود.
روند کار با سونوگرافی واژینال استارت میخورد. متخصص تصویر فولیکولهای بالغ را روی مانیتور میبیند و سپس یک سوزن باریک را از دیواره واژن وارد مسیر مشخصی نموده تا به تخمدان برسد.
داخل هر فولیکول، مایع فولیکولی و اووسیت قرار گرفته است. دستگاه مخصوص، مایع را مکش میکند و آن را به آزمایشگاه جنینشناسی میفرستد. جنینشناس همان لحظه تخمکها را زیر میکروسکوپ پیدا میکند و کیفیت آنها را ارزیابی میکند.
پانکچر اغلب تحت بیهوشی کوتاهمدت انجام میشود؛ نه آنقدری عمیق که نیاز به مراقبتهای سنگین داشته باشد و نه آنقدری سبک که فرد چیزی احساس کند؛ پس بدون درد است. در بیشتر موارد تمام فرآیند کمتر از 15 دقیقه زمان میبرد.
این عمل را میتوان نقطه وصل بین تلاشهای چند هفتهای مثل تحریک تخمدان، تزریق HCG و پایش مداوم فولیکولها دانست. بدون پانکچر، هیچ تخمکی برای لقاح وجود نخواهد داشت و هیچ چرخهای به مرحله انتقال جنین نمیرسد.
عمل پانکچر برای چه کسانی انجام میشود؟
پانکچر تنها زمانی انجام میشود که تخمدانها تحت تاثیر داروهای تحریککننده، به مرحلهای برسند که فولیکولهای بالغ با اندازه استاندارد آماده برداشت باشند. در واقع، این عمل بخشی از روند معمول IVF بوده و بدون آن تخمکی برای باروری وجود نخواهد داشت.
کسانی که کاندید اصلی پانکچر هستند اغلب یک یا چند شرایط زیر را دارند:
- زوجهایی که بهدلیل مشکلات مختلف باروری به آیویاف نیاز دارند.
- زنانی که فولیکولسازی دارند اما مشکلی در عبور تخمک از لولهها وجود دارد.
- کسانی که دچار نارسایی لولههای فالوپ هستند و تنها مسیر ممکن، برداشت تخمک از تخمدان و لقاح در محیط آزمایشگاه است.
- کسانی که با وجود تخمکگذاری، احتمال باروری طبیعیشان پایین است و استخراج مستقیم اووسیت شانس لقاح را افزایش میدهد.
- زنانی که با تحریک تخمکگذاری، تعداد مناسبی فولیکول بالغ ایجاد کردهاند و باید قبل از تخریب طبیعی یا تخمکگذاری خودبهخودی، تخمکها برداشته شوند.
- کیفیت واقعی تخمک فقط پس از پانکچر مشخص میشود. برای همین این عمل نقطهای مهم در زنجیره درمان ناباروری محسوب میگردد.
آشنایی با مراحل پانکچر

چند ساعت پسش از شروع، فرد لازم است ناشتا باشد تا بیهوشی کوتاه بدون ریسک انجام گیرد. تیم درمان در این مرحله تمام اطلاعات مربوط به تحریک تخمدان و تعداد فولیکولهای بالغ را بررسی میکند.
- آمادهسازی پیش از عمل: ناشتایی، بررسی پرونده درمانی، سنجش تعداد فولیکولهای بالغ
- تزریق HCG: تعیین لحظه مناسب برای برداشت تخمک
- ورود به اتاق عمل: اتصال مانیتورینگ و آمادهسازی برای بیهوشی کوتاه
- بیهوشی کوتاهمدت: ورود به حالت کاملا بدون درد
- هدایت سوزن با سونوگرافی واژینال: تعیین مسیر دقیق تا تخمدان
- مکش مایع فولیکولها: انتقال فوری به آزمایشگاه جنین
- پیدا کردن اووسیتها: بررسی کیفیت تخمک در لحظه
- انتقال به ریکاوری: چکاپ اولیه، برگشت هوشیاری، تحویل توصیههای بعد از عمل
مدت زمان عمل پانکچر چقدر است؟
در واقع، پانکچر یکی از سریعترین مراحل درمان ناباروری است، اما همین چند دقیقه کوتاه کیفیت کل چرخه IVF را تعیین میسازد. زمانی که بیمار وارد اتاق عمل میشود، بیهوشی کوتاهمدت تزریق شده و بدن ظرف چند ثانیه وارد حالت آرام و بدون درد میشود.
بخش اصلی عمل، یعنی ورود سوزن و تخلیه فولیکولها، در شرایطی انجام میشود که پزشک با سونوگرافی واژینال مسیر را لحظهبهلحظه روی مانیتور میبیند. تعداد فولیکولها اغلب تعیینکننده طول عمل است.
در صورتی که فولیکولها کم باشند، روند پانکچر سریعتر تمام میشود. اگر تعداد زیادی فولیکول بالغ وجود داشته باشد، هر فولیکول باید بهصورت جداگانه تخلیه شده و چند دقیقه به زمان اضافه میشود. با وجود این تفاوتها، بخش عمده عمل کمتر از ربع ساعت طول میکشد و فرد پس از پایان کار به بخش ریکاوری منتقل میشود.
آیا عمل پانکچر درد دارد؟
به طور معمول عمل پانکچر درد شدیدی ایجاد نمیکند، اما کمی احساس فشار یا ناراحتی خفیف در محل وارد شدن سوزن کاملا طبیعی است. متخصصان با کمک بیحسی موضعی و روشهای دقیق، درد بیمار را به حداقل میرسانند.
عمل پانکچر یک روش کمتهاجمی برای نمونهبرداری از بافت یا مایع بدن محسوب میشود. شدت درد به عوامل متعددی بستگی دارد، از جمله نوع پانکچر، محل انجام آن، اندازه سوزن و تجربه پزشک.
- پانکچر نخاعی: بیمار ممکن است احساس فشار یا کشیدگی در پشت یا پاها داشته باشد، اما درد شدید نادر است.
- پانکچر استخوانی یا کبد: کمی درد در زمان ورود سوزن ممکن است وجود داشته باشد، که با بیحسی موضعی کاهش مییابد.
- مدت زمان درد: بیشتر ناراحتیها طی چند دقیقه پس از ورود سوزن فروکش میکنند.
پزشکان اغلب پیش از شروع، محل را ضدعفونی و بیحس میکنند تا حداقل ناراحتی احساس شود. از سوی دیگر، تکنیکهای آرامسازی بیمار و تنفس عمیق میتوانند کمک نمایند که تجربه پانکچر راحتتر شود. برای خرید مولتی پلاس بانوان یوروویتال کلیک کنید.
آشنایی با انواع عمل پانکچر

باید بدانید که عمل پانکچر انواع مختلفی داشته که بسته به محل نمونهبرداری و هدف تشخیصی انتخاب میشود. شایعترین انواع آن شامل پانکچر نخاعی، پانکچر استخوانی و پانکچر کبد است. هر نوع ویژگیها، ریسکها و کاربردهای خاص خود را دارد.
پانکچر یک روش پزشکی است که با استفاده از سوزن نازک برای جمعآوری نمونه از مایعات یا بافتهای بدن انجام میگیرد. بسته به هدف، انواع متفاوتی وجود دارد:
- پانکچر نخاعی
جمعآوری مایع مغزی-نخاعی برای تشخیص عفونت، خونریزی یا بیماریهای عصبی. بیحسی موضعی انجام میشود و درد اغلب خفیف است.
- پانکچر استخوانی
جمعآوری نمونه مغز استخوان جهت تشخیص سرطان خون، کمخونی یا اختلالات مغز استخوان. ممکن است کمی احساس فشار یا درد داشته باشید.
- پانکچر کبد
نمونهبرداری از بافت کبد برای بررسی بیماریهای کبدی مانند هپاتیت یا فیبروز. با بیحسی موضعی انجام میگیرد و نیاز به مراقبت بعدی خواهد داشت.
- پانکچر سایر اندامها
شامل پانکچر کلیه، پانکچر پانکراس یا پانکچر تومورهای سطحی. انتخاب سوزن و تکنیک بسته به محل انجام میشود.
همچنین پیشنهاد میشود مقاله صفر تا صد فیبروم رحم و روش تشخیص آن را نیز مطالعه نمایید
بعد از پانکچر چه مراقبتهایی لازم است انجام شود؟
پس از انجام پانکچر، بدن شما نیاز به زمان کوتاهی به منظور بهبود دارد. رعایت موارد زیر به کاهش ریسک عوارض و افزایش راحتی شما کمک مینماید:
- استراحت کوتاه
بسته به نوع پانکچر، اغلب چند ساعت استراحت توصیه میشود. برای پانکچر نخاعی، دراز کشیدن به پشت تا چند ساعت میتواند از سردرد و ناراحتی جلوگیری کند.
- دوری از فعالیتهای سنگین
حداقل 24 ساعت پس از پانکچر از ورزش شدید، بلند کردن اجسام سنگین یا فعالیتهایی که فشار روی محل پانکچر میآورد، خودداری کنید.
- پیگیری علائم غیرطبیعی
سردرد شدید، تب، خونریزی یا تورم غیرمعمول ممکن است نشانه عارضه باشد و نیازمند بررسی فوری پزشکی است.
- مراقبت از محل پانکچر
محل ورود سوزن را تمیز و خشک نگه دارید. در صورت مشاهده قرمزی، تورم یا خونریزی غیرطبیعی، به پزشک مراجعه نمایید.
- داروها و توصیههای پزشکی
پزشک ممکن است داروهای مسکن سبک یا توصیههای خاص دیگری برای کاهش درد ارائه دهد. لازم است دستورالعملهای پزشک را دنبال کنید.
- نوشیدن مایعات کافی
مصرف آب و مایعات به ویژه پس از پانکچر نخاعی میتواند به کاهش سردرد و بهبود سریعتر کمک کند.
بررسی خطرات و عوارض پانکچر

همانطور که در بخشهای قبلی هم گفتیم، پانکچر یک روش کمتهاجمی محسوب میشود، اما برخی عوارض احتمالی وجود دارند که بیمار باید از آنها مطلع باشد:
- درد و ناراحتی محل پانکچر
شایعترین عارضه است و اغلب طی چند ساعت تا چند روز برطرف میگردد. مصرف از مسکنهای سبک و مراقبت از محل پانکچر به کاهش آن کمک میکند.
- سردرد پس از پانکچر نخاعی
در حدود 10-20٪ بیماران ممکن است سردرد ناشی از کاهش فشار مایع مغزی-نخاعی رخ دهد. این سردرد معمولاً با استراحت، نوشیدن مایعات و در برخی موارد با درمانهای پزشکی کاهش مییابد.
- خونریزی یا کبودی
خونریزی سطحی یا کبودی در محل ورود سوزن ممکن است دیده شود، به ویژه در بیماران با اختلالات خونریزی یا مصرف داروهای رقیقکننده خون.
- عفونت
احتمال عفونت بسیار کم است، اما رعایت بهداشت و ضدعفونی محل پانکچر مهم است.
- آسیب به بافت یا اندامها
عارضه نادر، اما در صورت انجام نادرست پانکچر ممکن است به بافت مجاور آسیب جزئی وارد شود. انتخاب پزشک مجرب و تکنیک درست، ریسک این عارضه را به حداقل میرساند.
- علائم جدی نادر
بیحسی طولانی، تب بالا، تورم شدید یا مشکلات عصبی باید فورا به پزشک گزارش شود.
باید بدانید که اکثر عوارض پانکچر خفیف و کوتاهمدت هستند و با مراقبت مناسب و پیگیری پزشک، بهبود مییابند.
سخن پایانی
در نهایت، دیدیم که عمل پانکچر، روشی برای تشخیص دقیق و درمان بهموقع بیماریهاست. این روش کمتهاجمی و مطمئن، به پزشکان کمک میکند تا با دقت بالا و خطر حداقلی، اطلاعات بسیار مهمی درباره وضعیت سلامت بیمار به دست آورند. برای خرید کپسول راتاهیل کلیک کنید.
سوالات متداول درباره عمل پانکچر
1. پانکچر چه مدت طول میکشد؟
اغلب بین 10 تا 30 دقیقه. مدت زمان دقیق به نوع پانکچر و محل نمونهبرداری بستگی خواهد داشت. پانکچر نخاعی و استخوانی اغلب 15 تا 30 دقیقه طول میکشد، در حالی که پانکچر کبد یا اندامهای دیگر ممکن است کمی سریعتر انجام شود.
2. آیا پانکچر خطری هم دارد؟
اکثر پانکچرها کمخطر هستند. پانکچر یک روش کمتهاجمی بوده که توسط پزشکان مجرب انجام میگیرد. با مراقبتهای پس از عمل و رعایت بهداشت، خطر عوارض جدی بسیار پایین است.
3. بعد از پانکچر چه مراقبتهایی لازم است؟
پاستراحت، مراقبت از محل پانکچر و پیگیری علائم غیرطبیعی. بیماران لازم است چند ساعت استراحت کنند، محل پانکچر را تمیز و خشک نگه دارند، از فعالیت سنگین اجتناب کنند و در صورت مشاهده خونریزی، تب یا درد شدید به پزشک مراجعه نمایند.
4. آیا پانکچر دردناک است؟
درد شدید اغلب رخ نمیدهد. بیشتر بیماران تنها احساس فشار یا ناراحتی خفیف دارند. استفاده از بیحسی موضعی و تکنیکهای آرامسازی کمک میکند که تجربه پانکچر راحتتر شود.
5. چه زمانی باید به پزشک مراجعه کنیم؟
در صورت علائم غیرطبیعی یا طولانی شدن درد. سردرد شدید، خونریزی زیاد، تورم غیرمعمول، تب یا بیحسی طولانی مدت نشانههایی هستند که نیاز به بررسی فوری پزشکی دارند.
منبع: wikipedia






(0) دیدگاه